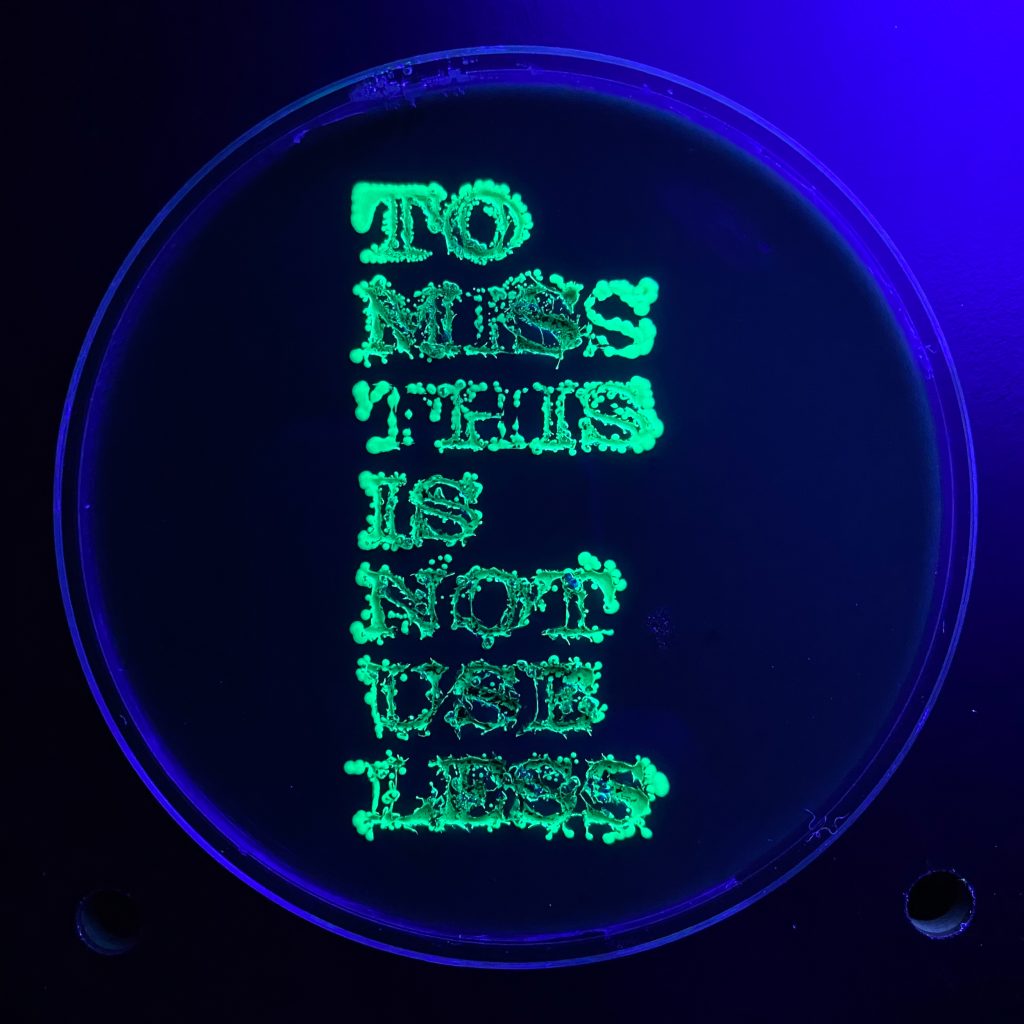
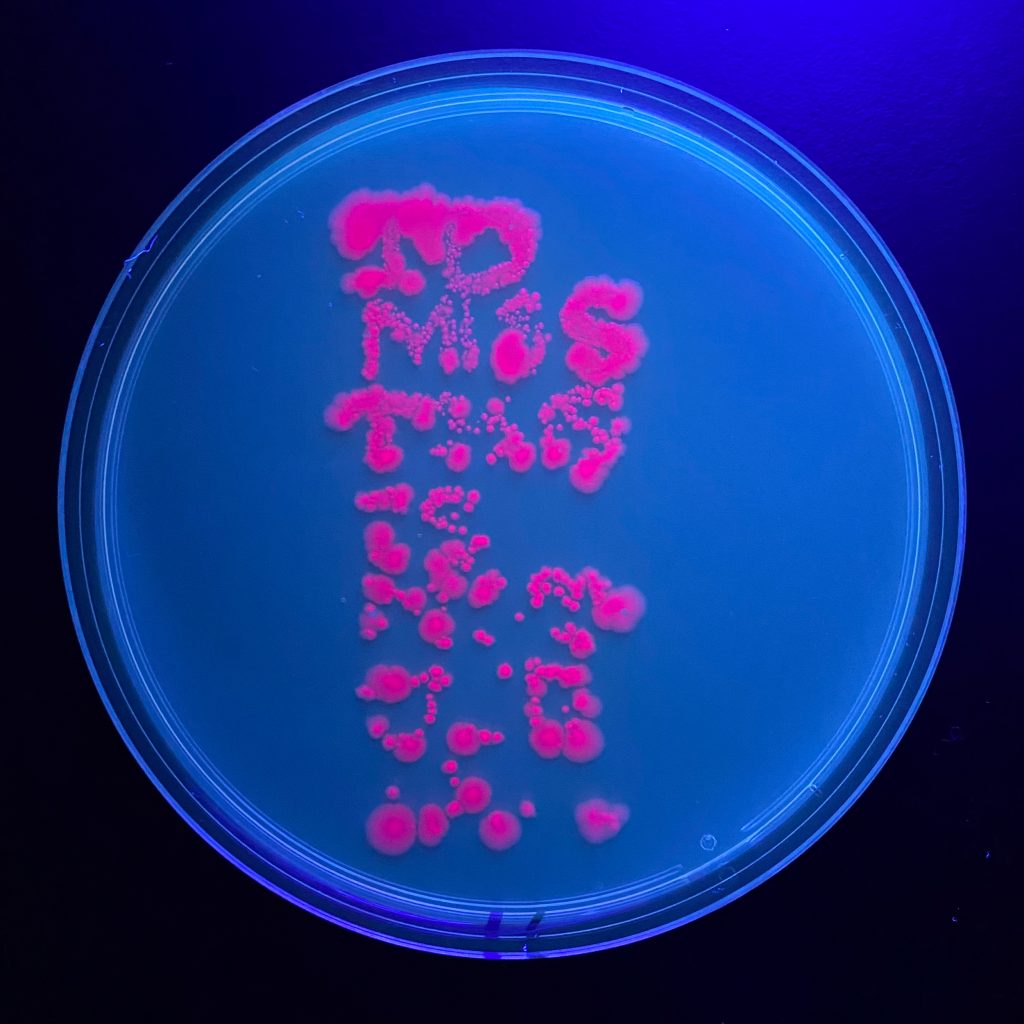
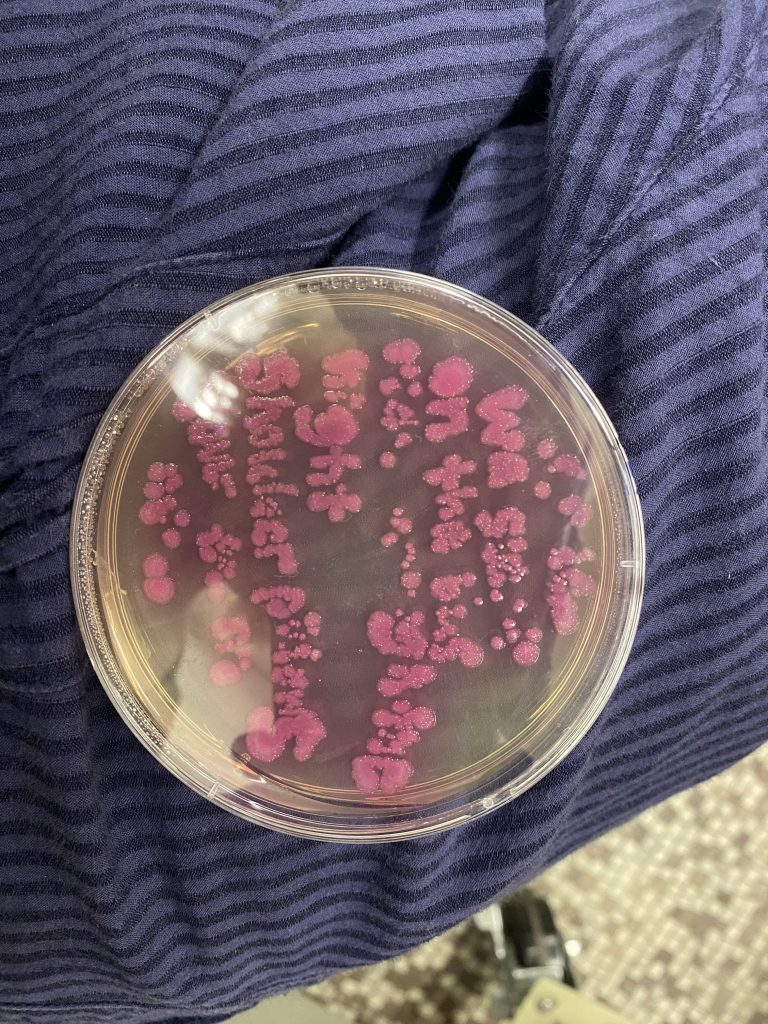
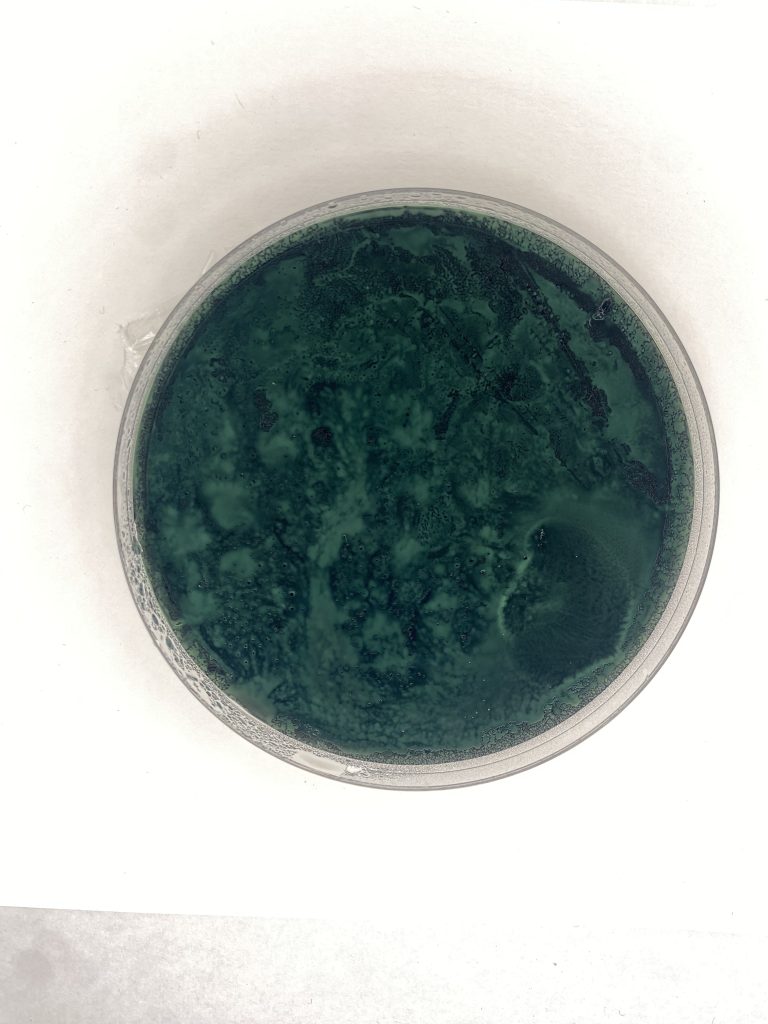

Clara Kuehnel, Interdisciplinary Sculpture, 2026
Project Overview
to miss this is not useless, 2025.
2-day timelapse of genetically engineered e. coli growth; series of inscriptions in amajlime e.coli, RFP e.coli, rusted steel, rust print on cheesecloth.
considerations on reminiscing, growth and decay.

Process
I wanted to take a timelapse of the genetically modified e. coli growing the phrase “to miss this is not use less,” originally planning to bioprint the fluorescent amajlime e.coli onto an antibiotic charcoal agar plate and film its growth. After a practice run with the bioprinter where the toothpick tip ended up dragging in & cutting into the agar, we spent ~3-4 hours adjusting the plane and running the bioprinter repeatedly to get a good print onto the uneven surface of the agar plate. However, the timelapse of that plate failed, due to having left the plate too open/introduced to airflow in an attempt to reduce condensation that would obstruct the filming – the agar completely dried up & nothing grew… (file is too big to upload onto site 🙁 )
In my next attempt, I simply hand-drew the phrase with a cell-spreader loop, in RFP e.coli onto a clear plate from Amaya. This time, when placing the inoculated plate inside a larger petri-dish, we propped up the lid slightly with small rubber blocks around the perimeter of the larger dish, allowing some natural airflow to not trap condensation, but not so much as to ruin the moisture of the agar. This iteration of the timelapse was a success!! Additionally, in running both timelapses, I left my phone filming in the incubator with the plates from Saturday – Tuesday (truly a test of weaning my reliance on my devices).
As parts of my series of the phrase, I included both the results of the successful RFP timelapse and the growth of the initial practice bioprint, as well as a rust print and the collection of CNC-cut, then rusted steel letters.
plus some other tests, with the cell spreader loop and with laser-cut stencils

Learn More
@placebopilled on instagram